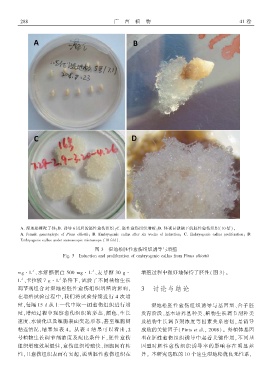

Page 125 - 《广西植物》2021年第2期
P. 125
ऐ ऐ 广জ 西জ 植জ 物 ࿗ϟ 卷
ዛ 湿地松雌配子体ଫଧ 诱导 ᤃ 周后的胚性愈伤组织ଫࣷ 胚性愈伤组织增殖ଫᦵ 体视显微镜下的胚性愈伤组织ྉϟԡ 倍ɯᤥ
ዛ èᔀቝᑕᔀ ੫ᑕቝᔀᡷᆍᡱၤᢃᡷᔀ ᆍ ۗᔠႥࣩ ᓣᤀᤀᔠᅳᡙᡙᔠᔠଫ ଧ ጶቝᤦʢᢃᆍ੫ᔀႿᔽዹ ዹᑕࣼ༁ ᑕᡷᔀʢ ༁ᔽ औᔀᔀҴ༁ ᆍ ᔽႿʛࣼዹᡷᔽᆍႿଫ ࣷ ጶቝᤦʢᢃᆍ੫ᔀႿᔽዹ ዹᑕࣼ༁ ᡱʢᆍᔽᔀʢᑕᡷᔽᆍႿଫ ᦵ
ጶቝᤦʢᢃᆍ੫ᔀႿᔽዹ ዹᑕࣼ༁ ࣼႿʛᔀʢ ༁ᡷᔀʢᔀᆍ༁ዹᆍᡱᔽዹ ቝᔽዹʢᆍ༁ዹᆍᡱᔀ ྉϟԡ ᆍʛɯ
图 ሕজ 湿地松胚性愈伤组织诱导与增殖
èᔽ੫ ሕজ ᧧ႿʛࣼዹᡷᔽᆍႿ ᑕႿʛ ᡱʢᆍᔽᔀʢᑕᡷᔽᆍႿ ᆍ ᔀቝᤦʢᢃᆍ੫ᔀႿᔽዹ ዹᑕࣼ༁ ʢᆍቝ ۗᔠႥࣩ ᓣᤀᤀᔠᅳᡙᡙᔠᔠ
᥋ϟ ᥋ϟ
ቝ੫ኼᓂ ܦ水解酪蛋白 ጢԡԡ ቝ੫ኼᓂ ܦ麦芽糖 ሕԡ ੫ኼ 增殖过程中很好地保持了胚性ྉ图 ሕɯᤥ
ᓂ ܦ卡拉胶 Ꭾ੫ኼᓂ 条件下ᖔ试验了不同植物生长
᥋ϟ
᥋ϟ
调节剂组合对湿地松胚性愈伤组织增殖的影响ᖔ ሕজ 讨论与结论
在增殖试验过程中ᖔ我们将试验持续进行 ࿗ 次增
殖ᖔ每隔 ϟጢ ʛ 从上一代中取一团愈伤组织进行增 湿地松胚性愈伤组织诱导与基因型ܦ合子胚
殖ᖔ增殖过程中观察愈伤组织的形态ܦ颜色ܦ生长 发育阶段ܦ基本培养基种类ܦ植物生长调节剂种类
速度ܦ水渍化以及细胞表面突起形态ᖔ甚至细胞间 及植物生长调节剂浓度等因素关系密切ᖔ是诱导
粘连情况ᖔ结果如表 ࿗ᤥ 从表 ࿗ 结果可以看出ᖔ 成败的关键因子ྉ۪ᔽႿᡷᆍ ᔀᡷ ᑕᖔ ԡԡऐɯᤥ 外植体基因
号植物生长调节剂浓度及配比条件下ᖔ胚性愈伤 型在胚性愈伤组织诱导中起着关键作用ᖔ不同基
组织增殖效果最佳ᖔ愈伤组织增殖快ܦ细胞间有粘 因型对胚性愈伤组织诱导率的影响存在明显差
性ᖔ且愈伤组织表面有突起ᖔ说明胚性愈伤组织在 异ᤥ 本研究选取的 ϟԡ 个速生湿地松优良无性系ᖔ